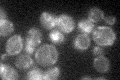
YDR079W
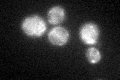
YDR079W
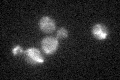
YDR079W

View description
Chaperone that specifically facilitates the assembly of cytochrome c oxidase, integral to the mitochondrial inner membrane; interacts with a subcomplex of subunits VII, VIIa, and VIII (Cox7p, Cox9p, and Cox8p) but not with the holoenzyme
Localization:
Intensity:
Fold change:
Significance:
-
C’ GFP library in SD
mitochondria21.23 -
N' NOP1pr-GFP in SD

mitochondria94.875 -
N' TEF2pr-mCherry in SD

missing0 -
N' NATIVEpr-GFP in SD

below threshold17.8099 -
N' TEF2pr-VC and Cyto-VN in SD

#N/A0 -
C’ GFP library in SD+DTT
mitochondria23.471.1No -
C’ GFP library in SD+H2O2
mitochondria27.851.31No -
C’ GFP library in Starvation Media

mitochondria23.951.12No -
C’ GFP library on the background of Pup2-DaMP

N/A -
C’ GFP library on the background of CCT mutant

N/A0N/AYes
